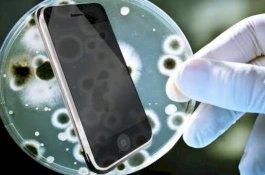
Kuman Ponsel Tiga Kali Lebih Kotor dari Toilet, Begini Cara Membersihkannya

Berita/Artikel
Tabrak Truk yang Sedang Parkir di Barru, Dua dari 7 Penumpang Minibus Tewas
News
- 15 Maret 2020 17:41
Sudah 117 Orang Positif Corona di Indonesia, Ini Pernyataan Lengkap Presiden Jokowi
News
- 15 Maret 2020 17:24
Arab Saudi Isolasi Uang Kertas yang Dikirim dari Luar Negeri, UEA Tutup Klub Malam
News
- 15 Maret 2020 08:00
Markas Perumahan Pasukan AS Diserang 25 Roket Pagi-Pagi, Lima Orang Terluka
News
- 15 Maret 2020 06:00
Positif Virus Corona, Menhub Sempat Berkelakar Kebal karena Nasi Kucing
News
- 15 Maret 2020 05:00
Anniversary Kedua, Komunitas Motor di Pangkep Ini Bagi-Bagi Sembako ke Duafa
News
- 14 Maret 2020 23:58
300 Rider Jelajahi Wisata Alam Bantaeng, Diramaikan Legislator Didik Sugiharto
News
- 14 Maret 2020 23:15
Ke Kebun Cari Obat, Penyintas Kanker di Jeneponto Ditemukan Tewas 6 Hari Kemudian
News
- 14 Maret 2020 22:48
Pemkot Palopo Gelar Turnamen Sepak Takraw Antarklub, Ada Peserta dari Kalimantan
News
- 14 Maret 2020 22:17
Putrinya Dilecehkan Kelompok Pemuda, Ayah di Bulukumba Malah Ditahan Polisi
News
- 14 Maret 2020 21:53
Wanita yang Bawa Kabur Mobil Orang Mengaku Beyonce saat Ditangkap, Begini Reaksi Polisi
News
- 14 Maret 2020 20:01
Suami Main Serong, Istri Robohkan Rumah Hasil Banting Tulang di Luar Negeri
News
- 14 Maret 2020 19:42
Barcelona Tangguhkan Seluruh Aktivitas, Lionel Messi Cs Latihan di Rumah Masing-Masing
Bola
- 14 Maret 2020 18:01
Marah kepada China, Shoaib Akhtar: Kenapa Anda Makan Kelelawar, Anjing, dan Kucing?
News
- 14 Maret 2020 17:41
Adnan Harap Sekretariat PPK Kawal Proses Administrasi Tahapan Pilkada Gowa 2020
News
- 14 Maret 2020 16:51
Dokter dan Perawat Terinfeksi Virus Corona, Anies Baswedan Tutup Seluruh Sekolah di DKI
News
- 14 Maret 2020 16:31
Panjat Perbatasan Meksiko-AS, Wanita Hamil 8 Bulan Jatuh dalam Gelap Gulita
News
- 14 Maret 2020 08:00
Video Pria Tiongkok Diturunkan Sopir Taksi di Tengah Jalan, Artis Mesir Ini Minta Maaf
News
- 14 Maret 2020 07:00
Kuman Ponsel Tiga Kali Lebih Kotor dari Toilet, Begini Cara Membersihkannya
News
- 14 Maret 2020 06:00
Populer